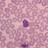
Malaria: Impfstoff erhöht Infektionsrisiko

EMA empfiehlt Malaria-Impfstoff
Der erste Impfstoff gegen Malaria steht kurz vor der Zulassung: Die Europäische Arzneimittelagentur (EMA) hat eine positive Bewertung für Mosquirix von GlaxoSmithKline (GSK) abgegeben. Das Vakzin soll nicht nur vor Malaria, sondern auch vor Hepatitis B schützen. Der Impfstoff, der bislang unter der Bezeichnung „RTS,S“ (Adjuvans-System AS01) bekannt war, bewahrt jedes dritte Kind vor Malaria.
Der Wirkstoff ist ein rekombinanter Impfstoff auf Proteinbasis: Er kombiniert Gene aus dem Circumsporozoiten-Protein (CSP) des Malaria-Parasiten mit dem viralen Hüllprotein des Hepatitis B Virus und einem chemischen Hilfsstoff, um die Reaktion des Immunsystems zu steigern. Durch die Induktion hoher Antikörpertiter werden die Parasiten blockiert, sodass diese nicht die Leber infizieren können.
Die EMA befasste sich im Rahmen eines Verfahrens zur Beurteilung von Arzneimitteln, die außerhalb der EU eingesetzt werden, mit dem Impfstoff. In diesem Verfahren wurde die Qualität, Sicherheit und Wirksamkeit des Impfstoffs bei Säuglingen und Kleinkindern im Alter von sechs Wochen bis 17 Monaten in den Malaria-Endemiegebieten geprüft und bestätigt.
Nach drei Impfstoffdosen und einer Auffrischungsimpfung lag der Impfschutz bei den Kleinkindern bei 36 Prozent und bei den Säuglingen bei 26 Prozent. Ohne die vierte Impfdosis lag die Wirksamkeit bei 28 Prozent bei den Kleinkindern und 18 Prozent bei den Babys. Die Ergebnisse waren in dem Fachmagazin „Lancet“ veröffentlicht worden.
Der Impfstoff wurde bei rund 6.500 Säuglingen zwischen sechs und zwölf Wochen und 9000 Kleinkindern im Alter von 5 bis 17 Monaten getestet. Beteiligt waren 13 afrikanische Forschungszentren in acht Ländern – Burkina Faso, Gabun, Ghana, Kenia, Malawi, Mozambik, Nigeria und Tansania.
Aus Sicht von Professor Dr. Peter Kremsner vom Universitätsklinikum Tübingen, der an der Studie in Afrika beteiligt war, ist die Wirksamkeit des Impfstoffs zwar nicht befriedigend, aber das Beste, was es nach 100 Jahren Forschung bislang gebe. „Bisher hatten wir immer nur null oder sogar eine schädliche Wirkung mit den verschiedenen Impfstoffkandidaten.“ GSK-Chef Andrew Witty sprach von einem „sehr bedeutenden Beitrag“ im Kampf gegen Malaria, der zwar nicht die endgültige Antwort auf Malaria sei, aber helfe, die Krankheit unter Kontrolle zu halten.
Ähnlich sieht es auch die EMA: Der Impfstoff biete zwar keinen kompletten Schutz und die Wirkung lasse mit der Zeit nach – aber auffällige Nebenwirkungen gab es während der Studie im Vergleich zur Kontrollgruppe immerhin kaum.
„Das positive Votum der EMA ist ein erster Schritt auf dem Weg, eine Impfung gegen Malaria zu etablieren“, so Professor Dr. Klaus Cichutek, Präsident des Paul-Ehrlich-Instituts (PEI). Nach Jahrzehnten der intensiven Forschung sei Mosquirix der erste Malariaimpfstoff, der eine positive Bewertung erhalten habe. Seit 1984 wird an dem Impfstoff geforscht.
Die Meinung der EMA wird nun in die Bewertung der Weltgesundheitsorganisation WHO einfließen. Deren Empfehlung, den Impfstoff in den afrikanischen Staaten einzusetzen, die von Malaria tropica besonders betroffen sind, soll im November folgen.
Ob das Mittel zugelassen wird, entscheiden aber die betroffenen Staaten selbst. Angewandt werden soll Mosquirix nur außerhalb der Europäischen Union. Weltweit lebt etwa jeder zweite Mensch in einem Malaria-Risikogebiet. Jedes Jahr sterben nach Schätzungen knapp 600.000 Menschen an Malaria.

APOTHEKE ADHOC Debatte